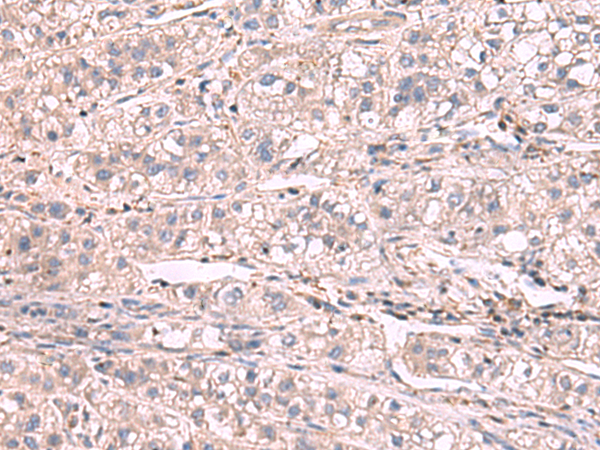

技術規(guī)格
Background:
This gene encodes a member of the family of cytosolic voltage-gated potassium (Kv) channel-interacting proteins (KCNIPs), which belong to the neuronal calcium sensor (NCS) family of the calcium binding EF-hand proteins. They associate with Kv4 alpha subunits to form native Kv4 channel complexes. The encoded protein may regulate rapidly inactivating (A-type) currents, and hence neuronal membrane excitability, in response to changes in the concentration of intracellular calcium. Alternative splicing results in multiple transcript variants encoding different isoforms.
Applications:
ELISA, IHC
Name of antibody:
KCNIP1
Immunogen:
Synthetic peptide of human KCNIP1
Full name:
potassium voltage-gated channel interacting protein 1
Synonyms:
VABP; KCHIP1
SwissProt:
Q9NZI2
ELISA Recommended dilution:
5000-10000
IHC positive control:
Human liver cancer and Human cervical cancer
IHC Recommend dilution:
50-300

購物車
幫助
021-54845833/15800441009
